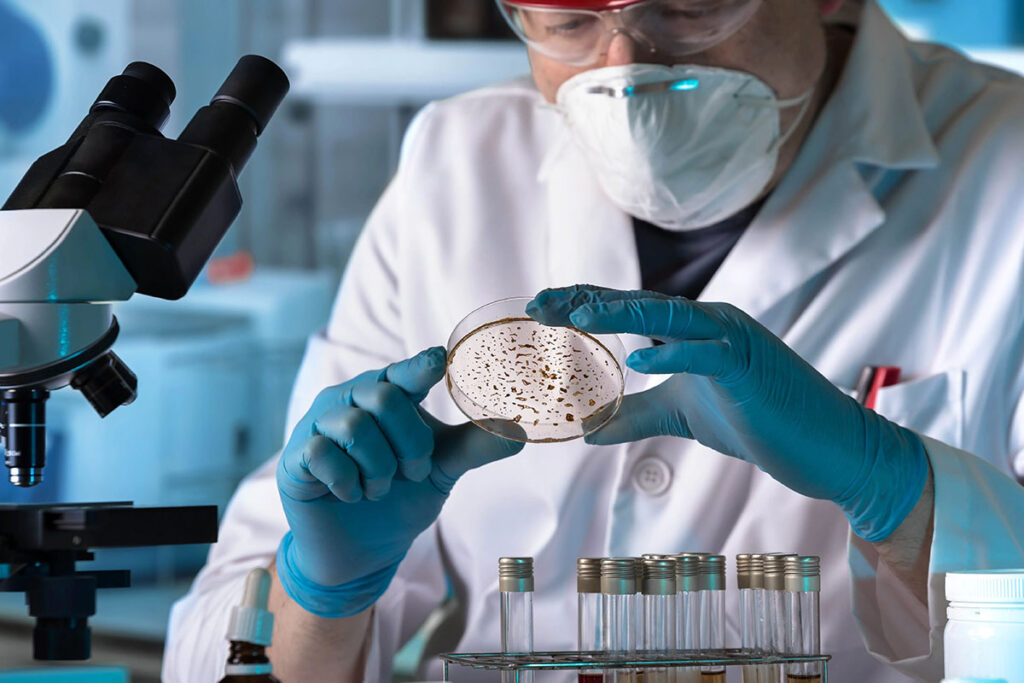
infectious-disease-research

Infectious Diseases – Island Hospital
SPECIALTY
Infectious Diseases
Infectious diseases can be serious, contagious, and difficult to diagnose. Our infectious disease doctors provide accurate testing and personalised treatment to help you recover safely and confidently.
Infectious Disease Centre in Malaysia
At Island Hospital, our Infectious Disease team is committed to the prevention, diagnosis, and treatment of complex infections. Whether you’re managing a long-term condition like HIV or dealing with an undiagnosed fever, our infectious disease doctors offer accurate assessments, advanced diagnostics, and comprehensive care.
We also provide pre- and post-travel health consultations, ensuring patients are well-prepared for both local and international travel. Our collaborative approach ensures you receive the most effective care possible.
Make An Inquiry if you have any more questions.
Conditions Treated for Infectious & Contagious Disease
Our Infectious Disease specialists are trained to diagnose and manage a wide range of infections caused by bacteria, viruses, fungi, or parasites. We also handle complex, drug-resistant, or unidentified infections. Conditions we treat include (but are not limited to) the following:
Bacterial Infections
- Tuberculosis (TB)
- Bloodstream infections (Sepsis)
- Bacterial respiratory infections such as pneumonia nad bronchitis
- Typhoid fever
- Skin and soft tissue infections
- Hospital-acquired bacterial infections such as MRSA and C. difficile
Viral Infections
- HIV and AIDS
- Hepatitis B and C
- Viral respiratory infections such as influenza and COVID-19
- Dengue fever
- Human Papillomavirus (HPV)
Fungal Infections
- Candidiasis
- Aspergillosis
- Fungal bloodstream or respiratory infections
Parasitic Infections
- Malaria
- Amoebiasis
- Giardiasis
Other or Mixed-Origin Infections
- Tropical and travel-related illnesses
- Fever of unknown origin
- Immunocompromised-related infections such as post-transplant infections and opportunistic infections
- Multi-drug resistant infections
Treatments and Services Offered
We offer a comprehensive range of services designed to detect, treat, and prevent infections across all age groups. Treatments and service offered at Island Hospital includes (but not limited to) the following:
- Advanced infectious disease testing to accurately identify infection types and sources.
- HIV screening, counselling, and long-term management
- Travel medicine services, including pre-travel vaccinations, medicine for travel and post-travel care.
- Management of rare or severe infections, including hospital-acquired infections.
- Coordination with other specialists for multi-disciplinary care.
- Antibiotic stewardship and guidance on antimicrobial use.
- Treatment plans tailored to patients with weakened immune systems or chronic illnesses.
Infectious Disease FAQs
Infectious diseases can spread through various means such as airborne droplets, direct contact, contaminated food or water, insect bites, blood and bodily fluids. Each disease has its own mode of transmission.
Symptoms vary depending on the infection but may include fever, fatigue, cough, rash, diarrhea, or body aches. Some infections can be asymptomatic or mimic other conditions. It’s recommended to consult a specialist for accurate diagnosis and personalised treatment.
You should consult an infectious disease specialist if you have a persistent or unexplained infection, are not responding to treatment, need travel-related health advice, or have a complex condition like HIV, TB, or hepatitis.
Not all infectious diseases are contagious. For example, foodborne illnesses may not spread from person to person, while illnesses like COVID-19 or the flu are highly contagious.
Practice good hygiene, stay up to date on vaccinations, avoid close contact with sick individuals, and take precautions during travel. Safe food and water practices are also key. If you have any suspected symptoms, please wear a mask and consult a doctor.